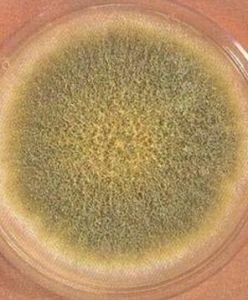
黴菌壁素 黴菌壁素

介紹
黴菌壁素黴菌也是真菌,能夠形成疏鬆的絨毛狀的菌絲體的真菌稱為黴菌。
黴菌和酵母廣泛分布於自然界並可作為食品中正常菌相的一部分。長期以來,人們利用某些黴菌和酵母加工一些食品,如用黴菌加工乾酪和肉,使其味道鮮美;還可利用黴菌和酵母釀酒、制醬;食品、化學、醫藥等工業都少不了黴菌和酵母。但在某些情況下,黴菌和酵母也可造成中腐敗變質。由於它們生長緩慢和競爭能力不強,故常常在不適於細菌生長的食品中出現,這些食品是pH低、濕度低、含鹽和含糖高的食品、低溫貯藏的食品,含有抗菌素的食品等。由於黴菌和酵母能抵抗熱、冷凍,以及抗菌素和輻照等貯藏及保藏技術,它們能轉換某些不利於細菌的物質,而促進致病細菌的生長;有些黴菌能夠合成有毒代謝產物-黴菌毒素。黴菌和酵母往往使食品表面失去色、香、味。例如,酵母在新鮮的和加工的食品中繁殖,可使食品發生難聞的異味,它還可以使液體發生混濁,產生氣泡,形成薄膜,改變顏色及散發不正常的氣味等。因此黴菌和酵母也作為評價食品衛生質量的指示菌,並以黴菌和酵母計數來制定食品被污染的程度。目前已有若干個國家制訂了某些食品的黴菌和酵母限量標準。我國已制訂了一些食品中黴菌和酵母的限量標準。